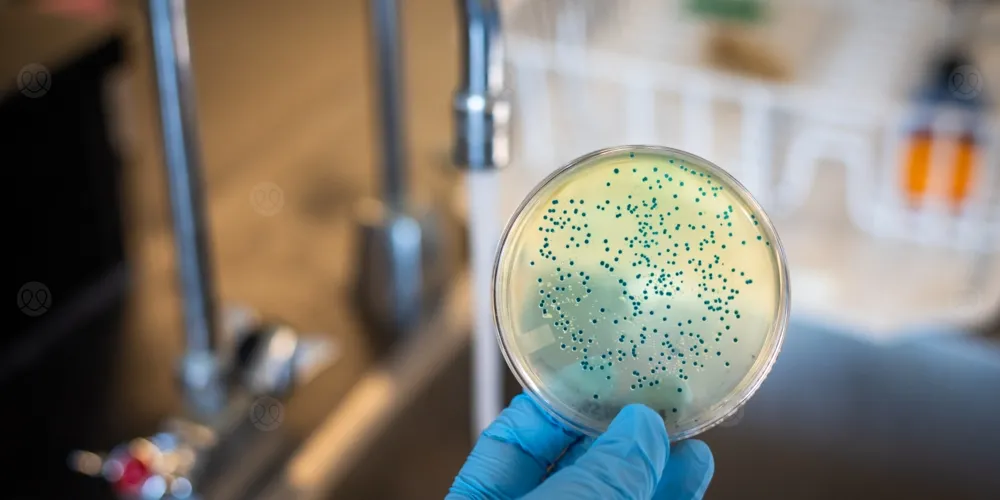
نظام غذائي قد يقلل خطر الإصابة بالكوليرا 100 مرة!

الكوليرا عدوى بكتيرية تصيب الأمعاء وتنتقل غالبًا عبر شرب مياه أو تناول أطعمة ملوثة، ويُمكن أن تُسبب مضاعفات خطيرة مثل الإسهال الحاد والجفاف الشديد إذا لم تعالج سريعًا، فهل يُمكن للأكل أن يقي منها؟ إذ كشفت دراسة حديثة نشرتها مجلة (Cell Host and Microbe) أن بعض الأنظمة الغذائية قد تُضعف قدرة بكتيريا الكوليرا على الاستقرار داخل الأمعاء بشكل كبير، مما قد يقلل العدوى إلى مستويات غير متوقعة، فكيف يحدث ذلك؟
منتجات الألبان والقمح: بروتينات تضعف الكوليرا
أظهرت نتائج الدراسة التي أجرتها جامعة كاليفورنيا- ريفرسايد أن الأنظمة الغذائية الغنية ببروتينات معيّنة كانت الأكثر فاعلية في الحد من نشاط بكتيريا الكوليرا، وعلى رأسها الكازين الموجود في منتجات الألبان، والغلوتين الموجود في القمح.
وأشار الباحثون إلى أن هذين النوعين من البروتينات كان لهما الدور الأكبر في إضعاف قدرة البكتيريا على الاستقرار داخل الأمعاء.
أي نظام غذائي يواجه الكوليرا بقوة؟ النتائج مفاجئة!
عند مقارنة أنماط غذائية مختلفة، وجد الباحثون أن الأنظمة الغنية بالدهون لم تُظهر تأثيرًا يُذكر، بينما قدّمت الأنظمة المعتمدة على الكربوهيدرات البسيطة فائدة محدودة فقط. في المقابل، برزت الأنظمة الغنية ببروتينات الحليب والقمح كالأكثر فاعلية، إذ ساهمت في تقليل استيطان بكتيريا الكوليرا داخل الأمعاء بشكل كبير جدًا، وصلت إلى 100 مرة أقل في بعض الحالات.
كيف يعطّل الغذاء آلية هجوم الكوليرا؟
يوضح الباحثون أن بعض البروتينات الغذائية قد تُعطّل آلية دقيقة تعتمد عليها بكتيريا الكوليرا تُعرف باسم نظام الإفراز السادس (T6SS)، وهي أشبه بإبرة مجهرية تمكّن البكتيريا من مهاجمة الميكروبات الأخرى والسيطرة على بيئة الأمعاء. وعند تعطّلها، تفقد البكتيريا جزءًا مهمًا من قدرتها على الانتشار والتسبب بالعدوى.
أمل جديد للوقاية من الكوليرا بتكلفة بسيطة
تُبرز هذه النتائج إمكانية الاعتماد على حلول غذائية بسيطة ومنخفضة التكلفة لتقليل خطر الإصابة بالكوليرا، خاصة في المناطق التي يتوفر بها العلاج بشكل محدود أو تعاني من نقص في المياه الصالحة للشرب. كما تتميّز هذه المقاربة بأنها لا ترتبط بمشكلة مقاومة المضادات الحيوية، ما يمنحها أهمية إضافية.
ولكن بما أنّ هذه الدراسة أُجريت على الحيوانات فقط، يؤكد الباحثون الحاجة إلى مزيد من الدراسات لمعرفة ما إذا كانت النتائج تنطبق على البشر، ومدى إمكانية اعتماد هذه الاستراتيجية كوسيلة وقائية في المستقبل.
نصيحة الطبي
في النهاية، قد لا يكون الطعام مجرد وسيلة للتغذية، بل أداة يمكن أن تلعب دورًا في الوقاية من بعض العدوى الخطيرة. ففهم العلاقة بين النظام الغذائي وبكتيريا الكوليرا يفتح بابًا جديدًا لاستراتيجيات بسيطة وفعّالة، خاصة في البيئات محدودة الموارد.
ورغم أن الطريق لا يزال يتطلب مزيدًا من الأبحاث، فإن هذه النتائج تطرح فكرة لافتة: ربما يبدأ جزء من الحماية من الأمراض… من اختياراتنا اليومية على المائدة.
 تسجيل دخول
تسجيل دخول